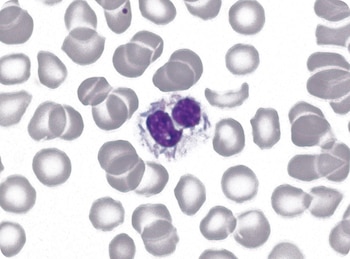
Capnocytophaga canimorsus

Un hombre alemán de 63 años murió luego de desarrollar una extraña enfermedad que se produjo después de que su perro lamiera su cara.
Los médicos lo consideraron un caso raro, ya que no es frecuente que el ser humano llegue a contagiarse por el trato común de sus mascotas.
Todo comenzó con lo que parecía una simple gripe, el hombre acudió al hospital e informó a los médicos sus síntomas, sin embargo se fueron agravando y desarrolló sepsis severa y púrpura fulminante, un trastorno agudo que causa manchas de sangre, hematomas y decoloración de la piel, así como necrosis.
El hombre fue tratado en cuidados intensivos, pero su salud continuó deteriorándose, desarrolló neumonía, falla hepática, sepsis severa y finalmentemurió de insuficiencia orgánica múltiple, se detalló en un artículo publicado en el European Journal of Case Reports in Internal Medicine.
La infección del hombre fue causada por capnocytophaga canimorsus, una bacteria que se encuentra comúnmente en la boca de perros y gatos. La bacteria se puede transmitir a través de una mordedura de animal pero también solo con que la saliva de las mascotas entren en contacto con heridas del cuerpo humano.
“Había sido tocado y lamido, pero no había sido mordido ni herido por su perro, su única mascota, en semanas anteriores”, se lee en el periódico, producido por médicos del Hospital de la Cruz Roja en Bremen, Alemania.
“Los dueños de mascotas con síntomas banales, como los de la gripe, deben buscar urgentemente consejo médico cuando los síntomas son inusuales”, escribieron los médicos.
La posibilidad de infección por C. canimorsus se debe considerar ante la presencia de un cuadro infeccioso grave en un paciente que ha sido mordido por un perro y obliga a tomar medidas urgentes, especialmente en individuos esplenectomizados o en tratamiento inmunosupresor, ya que pueden presentar una evolución rápidamente fatal.

Además, en el caso de pacientes alcohólicos y cirróticos se puede presentar con mayor facilidad un cuadro de sepsis fulminante con shock, coagulación intravascular diseminada, fallo renal e infiltrados pulmonares o meningitis.
La septicemia se asocia a mal pronóstico y alrededor de un 30% de los casos pueden acabar en muerte.
La bacteria es parte de la flora normal de las encías de perros y gatos. Sin embargo, aquellos con sistemas inmunes comprometidos, sobre todo los ancianos y las personas que han sufrido mordidas por animales, incluso aquellos que consumen alcohol en exceso o que se les ha extirpado el bazo, tienen un mayor potencial de infección.
En términos generales, suelen detectarse como positivos en un tiempo que oscila entre 24 horas y 14 días, con un tiempo medio de incubación de seis días.
Cuando los pacientes inmunodeprimidos son mordidos por sus mascotas comienzan a desarrollar la enfermedad, incluso algunas dentro del primer día en que aparecen los primeros síntomas, los cuales incluyen ampollas alrededor de la herida de mordeduras, enrojecimiento, hinchazón, pus, dolor, fiebre, diarrea, vómitos, molestias en los ojos, dolor de cabeza y dolor muscular. Sin embargo en algunos casos, lo síntomas tardan en aparecer.

A Greg Manteufel tuvieron que amputarle brazos y piernas
En otro caso médico, Greg Manteufel también se contagió de la misma bacteria, él no murió pero sí le tuvieron que cortar brazos y piernas.
Los síntomas comenzaron con fiebre y vómitos, como si tuviera la gripe. Pero a la mañana siguiente estaba delirando y su temperatura se había disparado.
Greg Manteufel sufrió una rara infección en la sangre luego de que bacterias dañinas de la saliva de un perro se filtraran en su torrente sanguíneo. Eso provocó sepsis o envenenamiento de la sangre por bacterias.
La sepsis dio lugar a manchas de sangre que parecían hematomas en todo su cuerpo, particularmente en el pecho y la cara. Los médicos lo ‘bombardearon’ con antibióticos para detener la infección, pero los coágulos bloquearon el flujo de sangre a sus extremidades, causando la muerte de los tejidos y los músculos.
Su esposa lo llevó rápidamente al hospital desde su casa de Wisconsin. Cuando llegaron, Dawn Manteufel relató que aparecieron moretones en todo su cuerpo y que no los tenía en el momento de salir de su casa, unos cinco minutos antes. Para Dawn fue como si acabasen de golpear a su marido con un bate de béisbol.
Después de una semana en el hospital, el hombre de 48 años, que pintaba casas para ganarse la vida y le encantaba montar en su motocicleta Harley-Davidson, perdió las piernas. Y después las manos.
Dawn explicó que la bacteria, llamada Capnocytophaga canimorsus, acababa de atacarlo y lo hizo de una manera rápida y agresiva. Para salvar su vida, los médicos tuvieron que cortarle las piernas desde la rodillas hacia abajo, y luego las manos.

Marie Trainer también fue víctima de esta bacteria
Marie Trainer despertó de un coma inducido y se dio cuenta que le faltaban sus extremidades. Había estado hospitalizada durante 10 días y en ese tiempo le amputaron parcialmente sus brazos y piernas.
Lo último que recordaba era que se había sentido enferma y se recostó en el sofá de su casa. Cuando abrió los ojos, se sentía confundida, no sabía dónde estaba y fue muy difícil descubrir lo que le había pasado.
Trainer es estilista y tiene es dueña de un salón de belleza, está casada y tiene hijos, vive en el condado de Stark, Ohio, en el medio oeste de Estados Unidos. Ella y su esposo, Matthew Trainer, acababan de regresar de unas vacaciones por el Caribe cuando enfermó.
Por los primeros síntomas que sintió, náuseas y un fuerte dolor de espalda, ella creyó que se iba a enfermar de gripe. Lo siguiente fue que su temperatura aumentó. Entonces su esposo decidió llevarla al hospital.
A pesar de que el equipo de cuidados críticos del Hospital Aultman le suministró un tratamiento agresivo, Trainer desarrolló una sepsis, un pacedimiento que da cuando el sistema inmune sobrerreacciona a una infección bacteriana, por lo cual su situación empeoró y tuvieron que cortar sus extremidades para salvar su vida.
MÁS DE OTROS TEMAS:
Una niña de 12 años se infectó con una bacteria come carne durante unas vacaciones en Florida
Últimas Noticias
La guerra con Irán sacude los mercados globales: el petróleo sube, las bolsas caen y el oro se desploma
Los ataques iraníes contra refinerías en Arabia Saudita, Kuwait y Qatar dispararon los precios del crudo más de un 60% desde el inicio de la guerra. La Fed mantuvo tasas y los mercados ya apuestan a que no habrá recortes en 2026
Las Fuerzas de Defensa de Israel atacaron buques lanzamisiles de la Armada iraní en el Mar Caspio
El operativo aéreo, en el que intervinieron varias agencias de inteligencia, fue dirigido contra instalaciones navales estratégicas, afectando la logística y el despliegue militar del régimen de Teherán en la región

Rumores de la participación argentina en Medio Oriente: el país “no puede desplegar fuerzas”, advirtió Serbin Pont
El analista internacional explicó que la Argentina no cuenta con capacidades militares ni logísticas para intervenir en el conflicto, en medio de versiones sobre un posible involucramiento tras los ataques de Irán a infraestructuras energéticas en la región

La inteligencia de Israel cree que el nuevo líder supremo de Irán no controla al régimen: “Una entidad vacía”
Mojtaba Khamenei no ha hecho ninguna aparición pública desde que asumió el cargo tras la muerte de su padre. Analistas israelíes describen un liderazgo “roto y confundido” en medio de la escalada bélica
Yacimientos en riesgo: cuáles son las refinerías clave que Irán amenaza con destruir en Medio Oriente
La escalada de ataques y represalias modifica el mapa de la infraestructura vital para la exportación de crudo y gas, generando incertidumbre en los mercados internacionales y comprometiendo la estabilidad de las cadenas industriales globales


